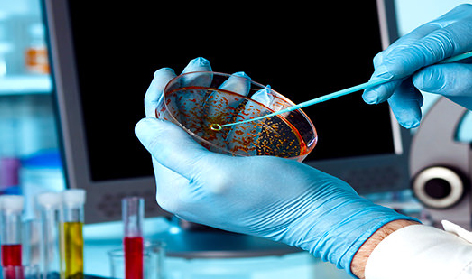

ACERTA Middle East
ACERTA Middle East is the Official Representitive of ACERTA Certification SL.in Africa and Middle East. ACERTA is an auditing and certification body in product certification
ACERTA Middle East is also a certification body for system certification QHSE & FSMS, truly independent and specialized in the food and other industries.
We invest much effort in training our team and in the standardization of evaluation criteria, which allows us to issue informs based on objective opinions. So our reports are accepted and highly regarded globally.
Company News

Academy
Our company is applied especially to the training and qualification of our internal staff and also to
Continue reading

Certifications
ACERTA Middle East conducts highly specialized audits based on our experience on the certification of the main ...
Continue reading

Inspection
QC include product inspection , where every product is examined visually, Quality control emphasizes
Continue reading
Laboratory
offers a comprehensive line of an anlytical testing services.We offer Quality Analysis, Superior Customer Service
Continue reading
Mission & Vision

Check Certificate number
Contact us
ACERTA MIDDLE EAST LTD. ( Head Quarter)
-
Villa 9030, Israa St.
Sunday through Friday - 9:00 AM - 5:00 PM CLT
Mogawra 9, Al Mearaj Al Sofly
Maadi, Cairo, Egypt -
+20223106707 +201020050188
-
E mails: [email protected]
-
Working Hours: Sunday through Friday - 9:00 AM - 5:00 PM CLT
Saturday - 10:00 AM - 3:00 PM CLT

